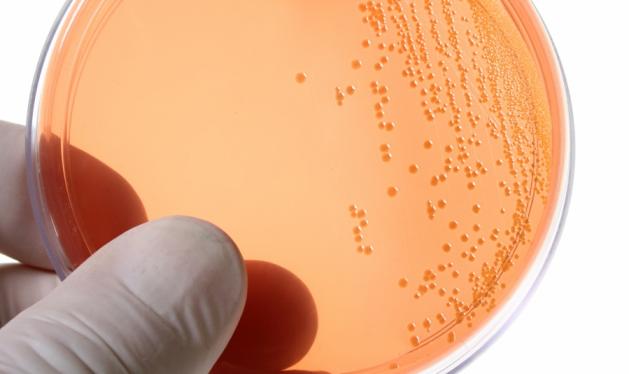

Για πρώτη φορά οι επιστήμονες κατάφεραν να δημιουργήσουν συκώτι από βλαστοκύτταρα, κάτι που δημιουργεί ελπίδες σε χιλιάδες ασθενείς που υποφέρουν από ηπατικές ασθένειες.
Η ομάδα επιστημόνων από τη Βοστόνη κατάφερε να δημιουργήσει μικρά συκώτια χρησιμοποιώντας βλαστοκύτταρα, τα θαυματουργά – και αμφιλεγόμενα για πολλούς – εκείνα κύτταρα που μπορούν να μετασχηματιστούν σε οτιδήποτε – από δέρμα μέχρι μυς και όργανα- με γενετική τροποποίηση.
ΔΙΑΦΗΜΙΣΗ
Οι ερευνητές “έχτισαν” τα βλαστοκύτταρα πάνω στο “ιχνος” ενός συκωτιού, δηλαδή ενός συκωτιού στο οποίο είχαν αφήσει μόνο το περίβλημα κολλαγόνου και ιστούς από κύτταρα αίματος. Το νέο όργανο αφέθηκε στον “βιοαντιδραστήρα” για να τραφεί με οξυγόνο και θρεπτικά συστατικά και να αναπτυχθεί ώστε να γεμίσει το περίβλημα.
“Είμαστε ενθουσιασμένοι με τις δυνατότητες που ανοίγονται από την έρευνα, ωστόσο πρέπει να τονίσουμε ότι είμαστε ακόμη σε πρώιμο στάδιο και υπάρχουν πολλά τεχνικά εμπόδια να ξεπεραστούν, ώστε να φτάσουμε να εξυπηρετούμε ασθενείς” δήλωσε ο καθηγητής Σάι Σόκερ.
ΔΙΑΦΗΜΙΣΗ
Ακολουθήστε το tlife.gr στο Google News και μάθετε πρώτοι όλα τα νέα.
ΔΙΑΦΗΜΙΣΗ
Top Stories 
ΔΙΑΦΗΜΙΣΗ